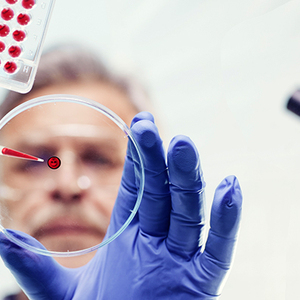

阿里否认收购Netflix
根据新浪科技消息,周五有传闻称,阿里巴巴准备提出收购Netflix。阿里巴巴随后对此表示否认。
阿里巴巴一名发言人表示:“我们没有准备对Netflix进行任何投资。”
在上周阿里巴巴收购传闻传出之后,Netflix股价周五大涨近4%,收于97.03美元。过去三个月,Netflix股价上涨9.5%,超过标准普尔500指数同期的6.5%。不过过去12个月中,Netflix股价下跌近22%,而标准普尔500指数同期上涨4%。
Netflix表示,不会对市场传闻或猜测置评,但该公司“对于中国市场的态度明确,在中国有着长期目标”。
三星向每位里约奥运选手赠送一部Galaxy S7 Edge

据国外媒体Android Authority的报道,作为里约奥运会的赞助商,三星将向每名参加里约奥运会的运动员赠送一台奥运限量版的Galaxy S7 Edge,并附赠新款的无线蓝牙耳机。
作为专门为里约奥运会量身打造的手机,三星S7奥运版在黑色机身的基础上融入了众多的奥运元素,正面的听筒和Home键、侧面的电源键、背部的摄像头和闪光灯边缘及音量键均是奥运色彩,背部还有引人瞩目的蓝色五环。
三星这笔赞助费用不小。本届里约奥运会的参赛运动员将达到12500人,那也就意味着三星将免费送出12500台奥运限量版的Galaxy S7 Edge。奥运限量版的Galaxy S7 Edge目前售价是849美元,因此三星此次免费赠送的手机价值超过1000万美元。
苹果二季度在印度市场iPhone出货量暴降35%
根据腾讯科技消息,市场研究机构Strategy Analytics的最新报告显示,苹果在印度市场严重受挫,第二季度出货量仅有80万部,较2015年同期的120万部相比,出货量下降了35%,而印度市场中的97%的智能手机运行的是谷歌的Android系统。
根据报告显示,印度市场2016年第二季度的手机出货量达到了3100万部,较去年同期的2580万部相比,同比增长19%。其中大约有超过97%的手机运行着Android系统,Android智能手机的出货量较去年同比增长28%。
今年的早些时候,苹果的CEO蒂姆·库克(Tim Cook)对印度进行了访问,并与印度总理进行了会面,库克曾表示:“纵观整个印度市场的发展,我们将会印度采取特殊的策略:我们将会继续关注iOS系统开发者社区的发展,在印度培养专业的人才。我们也将会在印度建立一个加速营,来帮助我们做这些事……我们相信在未来印度一定有跟其他市场一样的苹果零售店。”
苹果2亿美元收购人工智能创业公司Turi
根据新浪科技援引GeekWire网站报道称,苹果已收购位于西雅图的机器学习和人工智能创业公司Turi。该公司此前曾名为Dato和GraphLab。多名消息人士确认,Turi已被苹果收购。接近这笔交易的消息人士表示,收购价格约为2亿美元,这意味着早期投资者收益巨大。
这笔收购表明,苹果正大举进军人工智能和机器学习技术,而苹果在西雅图的业务规模也将扩大。过去两年,苹果正在西雅图建设工程中心。
Turi帮助开发者在应用中加入机器学习和人工智能技术。该公司的产品包括Turi机器学习平台、GraphLab Create、Turi Distributed,以及Turi预测服务。这些产品帮助不同规模的企业更好地利用数据。具体使用场景包括推荐引擎、反欺诈、预测用户数变化、情绪分析,以及用户分类等。